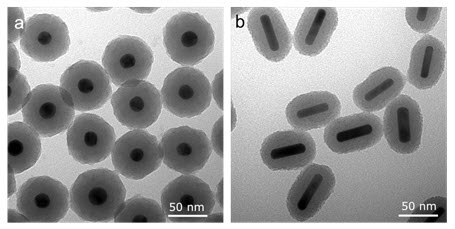

Silica-coated Gold Nanoparticles: Surface Chemistry, Properties, Benefits and Applications
Introduction
In the past few decades, research and commercial use of gold nanoparticles has rapidly expanded into fields extending from biomedical engineering1 to photovoltaics.2 Most applications take advantage of the excellent optical properties of gold nanoparticles, which can be fine-tuned by varying their shape and size.
However, uncoated gold nanoparticles are susceptible to aggregation in solution and can melt under laser irradiation, both of which cause significant changes in their optical properties. When their surface is properly passivated by chemical functionalization, they can resist aggregation and shape change under a wide range of biological, physical, and environmental conditions, allowing for the preservation of their optical properties. One such robust functionalization that has been proven to enhance gold nanoparticle stability both thermodynamically and chemically is silica coating.1,3,4 The excellent stability and functionality conferred by silica coating makes it a superior choice for many applications as described below.
Examples of silica coated gold nanospheres and nanorods are shown in Figure 1.
Figure 1. Scanning electron microscopy (SEM) image of (a) Silica-coated gold nanospheres and (b) silica-coated gold nanorods
Surface Chemistry and Synthesis of Silica-coated Gold
Silica coating of gold nanoparticles is accomplished using the classic Stöber method involving tetraethyl orthosilicate (TEOS) to form a highly branched and mesoporous siloxane polymer on the surface of gold. The reaction can be controlled such that the thickness of the layer of silica on the gold surface can be tailored with reaction time and reagent concentrations. The resulting siloxane polymer (termed silica) on the surface has hydroxyl (-OH) groups that can be used as chemical handles for further functionalization. Also, heterobifunctional silane linkers will readily react with silica, providing a means to attach a variety of ligands — like poly ethylene glycol (PEG) — to the surface of silica (Figure 2).

Figure 2. Silica-coated gold nanoparticle surface chemistry, showing a bare silica surface (left) with hydroxyl functional groups and a polyethylene glycol (PEG) coated nanoparticle that can be functionalized with different end groups including amines, thiols, maleimides, and N-hydroxysuccinimides, etc.
Properties and Benefits of Silica-coated Gold Nanoparticles
Silica coating of gold is advantageous in many applications involving gold nanoparticles. In particular, silica coating dramatically enhances the thermodynamic stability of gold nanorods when used in applications with pulsed lasers. Gold nanorods with standard coatings such as PEG, CTAB, or other small polymers can absorb enough energy from pulsed lasers to melt (Figure 3). This shape change leads to a corresponding shift in their absorption and scattering of light from the near infrared wavelengths to the visible spectrum.5 For applications where consistent near infrared light absorption is critical, gold nanorods with standard coatings may produce unreliable results. Alternatively, silica-coated gold nanorods resist shape change and can maintain their optical properties under much higher light intensity (fluence) levels (Figure 4).

Figure 3. Gold nanorods and optical properties shown before (left) and after pulsed laser exposure (right). Standard gold nanorods without silica coating are highly unstable and will melt in response to laser light absorption, degrading their absorption and scattering of light at near infrared wavelengths.

Figure 4. Absorbance spectrum of silica-coated gold nanorods after exposure to 300 pulses of 808 nm light at various levels of intensity (fluence). Silica-coated particles are thermodynamically stable (they resist shape change) for fluences up to 20 mJ/cm2.
In addition to thermodynamic stability (resisting melting) and colloidal stability, silica coating of gold nanorods imparts other notable properties and advantages. For instance, silica coating increases the surface area for conjugation of antibodies or other targeting moieties. Also, the silica is porous and can be loaded with drugs, dye molecules, or other imaging agents either via physical adsorption or covalent attachment. Silica coating also limits how close nanorods can pack at high concentrations, marginalizing the effects of plasmon coupling, and allowing for concentration-independent preservation of their optical properties. Lastly, the silica-coating on gold nanoparticles can enhance imaging contrast, such as in photoacoustic imaging, by more than 3 fold.1
PEGylated silica-coated gold nanoparticles (Figure 2 - right) can provide all the benefits of the silica coating along with properties associated with PEG-coated nanoparticles including higher colloidal stability and lower immunonogenicity.
Applications for Silica-coated Gold Nanostructures
1. Photoacoustic Imaging
When used as contrast agents in photoacoustic imaging (optoacoustic imaging), gold nanorods absorb light from a pulsed laser and generate substantial heat. Although this heat is required for the photoacoustic effect, it can reach deleterious levels that result in melting of the nanorods (Figure 2). This shape change leads to a reduction in absorption cross section, and therefore a loss of photoacoustic imaging contrast. Silica coating helps lower the interfacial thermal resistance between gold and the surrounding solvent (Figure 5), allowing the particle to release more heat to its environment, which has two positive effects: (1) gold particles can resist melting at high fluences (Figure 3), and (2) the photoacoustic signals generated from these particles are at least 3 fold greater than for gold nanoparticles with standard coatings such as PEG, CTAB, or other small polymers.1
Thermodynamically stable, silica-coated gold nanorods and nanospheres have been a popular choice for photoacoustic contrast and therapeutic agents due to their superior thermodynamic stability, optical properties, biocompatibility, and potential for bioconjugation.1

Figure 5.Schematic summary of the proposed thermal transport processes from the nanoparticle to the environment and the resulting temporal profiles of the temperature (T) near the surface and the amplitude of the photoacoustic signal (P) far from the surface of the nanoparticle. (a) A bare nanoparticle with high interfacial resistance leads to a broadened temperature profile and a smaller amplitude of the photoacoustic pressure signal. (b) Introducing a silica shell leads to a minimal interfacial resistance between gold (Au) and SiO2 and SiO2 and water. The resulting sharper temperature profile, and because the temperature profile is at a larger distance, the photoacoustic signal is increased. (c) A thick shell leads to a broadened temperature peak and again a decrease in the photoacoustic signal, although it may still be higher than that for the bare nanoparticle (Source: Reprinted with permission from Nano Letters 2011, 11 (2), pp 348–354. Copyright 2011 American Chemical Society)
2. Cell Tracking
Since photoacoustic imaging (optoacoustic Imaging) is noninvasive, quantitative, and has short scan times, it is an ideal tool for immune cell tracking8 and stem cell implantation tracking10 in conjunction with ultrasound imaging (Figure 6). Silica-coated gold nanorods can be used as contrast agents in photoacoustic imaging to quantify the implanted cells in real time and to confirm that an adequate number of cells have reached the treatment site. The silica coating also helps facilitate the cellular uptake of the gold nanorods.8

Figure 6.The first panel shows TEM images of SiO2-AuNRs (Silica-coated Gold Nanorods) with peak absorption 676 nm, silica-coating thickness 20 nm and the second panel confirms the presence of SiO2-AuNRs inside Mesenchymal Stem Cells after injection into muscle tissue of living mice; the third panel shows contrast-enhanced photoacoustic images of the intramuscular injection of SiO2-AuNRs -labeled mesenchymal stem cells into hind limb muscle of an athymic mouse (Source: Reprinted with permission from ACS Nano 2012 6 (7), 5920-5930. Copyright 2012 American Chemical Society)
Silica-coated gold nanorods are also used widely for photothermal therapy as they are small, have a tunable resonance in the red and near-infrared spectrum, and possess a very high absorption cross section. The silica coating increases the photothermal stability of gold nanorods, thus helping retain their superior optical properties under high continuous and pulsed laser fluencies.1,3,6 Silica-coated gold nanorods have also been shown to significantly increase cellular uptake over PEG-coated gold nanorods, which in turn translates into a better photothermal ablation effect.10 Furthermore, silica-coated nanorods can be used in conjunction with photoacoustic imaging to simultaneously create maps of heat generation during photothermal therapy that can guide its dosage and therapeutic efficacy.7
3. Targeted Drug Delivery
Silica-coated gold nanoparticles are biocompatible and can be chemically modified to specifically target cancerous tissues. Mesoporous silica-coated gold nanoparticles have been used as nanocarriers for anticancer drugs such as doxorubicin, DNA and protein due to their large surface area, tunable size, high accessible pore volume, drug loading capacity and well-defined surface properties that enable chemical modification (Figure 4). The combined chemo–photothermal therapy accomplished by drug loaded silica-coated gold nanorods has been shown to have an enhanced anti-cancer effect compared to both photothermal therapy and chemotherapy alone.11
4. Multiplex Imaging
Targeted silica-coated gold nanorods can be used as contrast agents in multiplex imaging to distinguish cell inclusions in vitro by targeting the nanoparticles to cells expressing different cell receptors12 (Figure 7). Silica-coated gold nanorods with different peak wavelengths can be used to label each unique cell type to identify the location of the specific cell types and generate images corresponding to molecular expression.

Figure 7. Signal processing and statistical analysis of the photoacoustic (PA) images acquired from the cell phantoms demonstrates the unique identification of the cell inclusions a) The inclusions can be seen in the ultrasound image. b) The PA image, acquired at 830 nM, indicates which inclusions contain silica-coated gold nanorods (SiO2-AuNRs). c) Comparison of PA signal intensity (points) and UV-VIS spectra (solid lines) demonstrates that the SiO2-AuNRs optical absorption spectra determine the PA signal intensity. Inclusions were segmented into three areas and the PA signal intensity was averaged d) Molecular map of cells and US overlay; 830 nM silica coated gold nanorods are shown in red, 780 nM SiO2-AuNRs are shown in yellow (Source: Reprinted with permission from Biomed Opt Express. Jul 1, 2011; 2(7): 1828–1835. Copyright 2011 Optical Society of America)
5. Dual Mode/Multimodal Imaging
Though optical imaging techniques are highly sensitive and can visualize diseased tissue with superior resolution, they are limited by the low penetration of light in tissue. Using a combination of complementary imaging modalities can help optimize both sensitivity and specificity. For instance, a contrast agent that simultaneously enhances CT contrast and near-infrared optical imaging can provide quantifiable information of contrast agent accumulation at different levels. Mesoporous silica-coated gold nanorods loaded with an organic NIR dye such as Indocyanine Green (ICG) can be used as an imaging probe for dual mode X-ray CT and NIR fluorescence imaging.13

Figure 8. In vivo planar X-ray images (exposure time 30 s) of a mouse prior to (a) and 12 h post intratumoral injection of indocyanine green-loaded silica-coated gold nanorods (200 μL, 1.5 mg/mL). (b) An in vivo planar X-ray image using a 60 s exposure time (left) taken 12 h post intratumoral injection of the dual mode imaging contrast agent was overlapped with the homologous near-infrared fluorescence image (10 s exposure time) (right). Inset: the corresponding overlay of bright field and near-infrared fluorescent images. The green arrow indicates the tumor. The thin layer of silica sandwiched between the gold nanorod and indocyanine green chromophores protected the dye from fluorescent quenching. (Source: Reprinted with permission from Optics Express, Vol. 19, Issue 18, pp. 17030-17039, 2011)
6. Surface Enhanced Raman Spectroscopy (SERS)
Dye-embedded silica-coated gold nanoparticles are highly efficient for surface Raman enhancement and can be used as spectroscopic tags for multiplexed detection and spectroscopy.14 The particles consist of a metallic core for optical signal enhancement, a reporter molecule for spectroscopic signature, and an encapsulating silica shell for protection and conjugation.

Figure 9. Schematic illustration of the core−shell nanoparticle structure and the procedure for preparing silica-coated SERS-active gold colloids. (a) Colloidal gold particles in the size range of 55−65 nM, optimized for surface Raman enhancement at 632−647-nM excitation; (b) gold particles with an adsorbed Raman reporter; (c) gold particles with both the reporter and mercaptopropyltrimethoxysilane (a common coupling agent); and (d) silica-coated gold particles with a Raman spectroscopic reporter embedded at the core−shell boundary (Source: Reprinted with permission from Anal. Chem., 2003, 75 (22), pp 6171–6176. Copyright 2003 American Chemical Society)
Silica-coated gold nanorods have also been used as dual-mode imaging probes for targeting cancer cells. Fluorescence and surface enhanced Raman scattering signals can be visualized independently by using different nanoparticle excitation wavelengths.17
7. Two-Photon Imaging
Mesoporous silica-coated gold nanorods that incorporate photosensitizers such as Pd-meso-tetra (4-carboxyphenyl) porphyrin (PdTPPs) can be used for two-photon-activated photodynamic therapy (Figure 10).16 The photosensitizer, doped into the nano-channels of the mesoporous silica shell, can be excited via intra-particle plasmonic resonance energy transfer from the encased two-photon excited gold nanorod and can generate cytotoxic singlet oxygen to kill cancer cells. By providing mechanical support against thermal deformation, the silica matrix can significantly improve the two-photon luminescence stability of the gold nanorod core.

Figure 10. In vivo studies illustrating two-photon activated photodynamic therapy following intra-tumor injection of mesoporous silica-coated gold nanoRod-PdTPPs. Histologic analyses of harvest tumor sections 24 hours post-irradiation were made with hematoxylin and eosin (first row) TUNEL (second row, green coloring), caspase-3 immuno-histogram (third row, red coloring) and DAPI (blue coloring) staining. Inhibition of tumor growth, indicated by staining with apoptosis indicators TUNEL and Caspase-3, was observed with combined mesoporous silica-coated Gold NanoRod-PdTPPs treatment and laser irradiation (1.2 times, figure 6i). (Source: Reprinted with permission from Theranostics. 2014; 4(8): 798–807)
8. Biomolecular Probes
Silica-coated gold nanoparticles can be used as labels for DNA hybridization assays to detect lower target DNA concentrations as compared to citrate-coated or standard gold nanoparticles due to the high emissivity of silica in the mid-infrared range. Fluorescence-based DNA hybridization and protein binding assays can be improved using silica-coated gold nanoparticles as robust labels that do not degrade, quench, or photobleach.17 This nanoparticle platform can also be employed to detect extremely low concentrations of proteins, bacteria, pesticides, and small molecules such as mercury.
9. Catalysts
For gold nanoparticles to be effective catalysts, they must be highly stable in the surrounding medium, in heat, and have recycling potential while maintaining catalytic activity. Typically, gold nanorods are coated with a surfactant called cetyltrimethylammonium bromide (CTAB). In organic solutions, the desorption of CTAB into the medium can cause aggregation of the gold nanorods and loss of their catalytic properties. Moreover, CTAB-coated gold nanorods can be thermodynamically unstable and this can induce transformation into spherical particles. Mesoporous silica-coated gold nanorods are highly effective as catalysts because the silica shell provides high stability in adverse conditions including heat, solvent exchange and centrifugation.18 Since mesoporous silica shells have large pore volumes, reactant molecules can diffuse through the pores and onto the gold surface for catalysis.
10. Photonics
Plasmonic gold nanoparticles are used in numerous photonics applications; these include single molecule detection, photonic crystal construction, and optical device design (e.g. waveguides). However, due to physical contact between the metal of neighboring bare gold nanoparticles, the formation of photonic band gaps is prevented. Coating the gold nanoparticles with an optically transparent, chemically inert and photochemically stable material – such as silica – allows for the creation of complete photonic band gaps when the plasmonic nanoparticles are organized in periodic structures.19 Additionally, the silica coating also helps with plasmonic fluorescence enhancement by inhibiting the quenching mechanism that occurs when flourophores are directly bound to a metallic surface. Thus, silica-coated gold nanoparticles offer multiple benefits over standard gold nanoparticles.
In summary, silica coating of gold nanoparticles can provide several beneficial properties including:
- Higher imaging signal strength in photoacoustic imaging & other modalities involving the use of pulsed lasers
- Superior thermal and colloidal stability
- Stable optical properties for a broader range of applications including multimodal imaging
- Theranostic capability facilitating use as hybrid drug carrier and imaging agent
- Flexible silane chemistry for covalent functionalization and conjugation
These unique advantages make them ideal for myriad applications as described in this tech spotlight.
Materials
References
To continue reading please sign in or create an account.
Don't Have An Account?